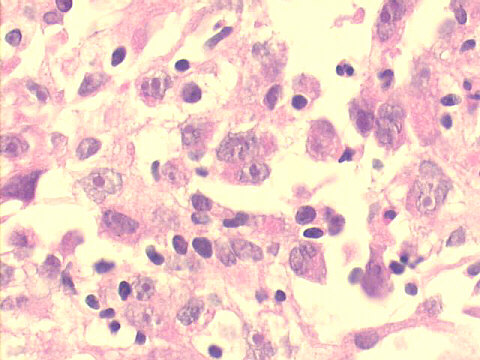
500x H&E staining
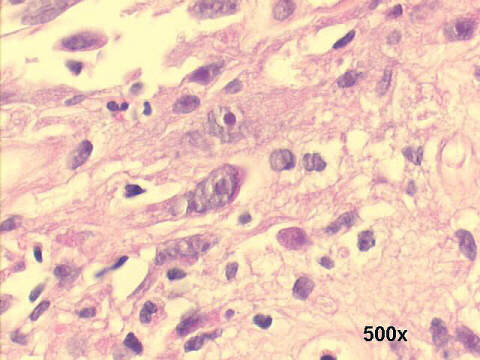
500x H&E staining
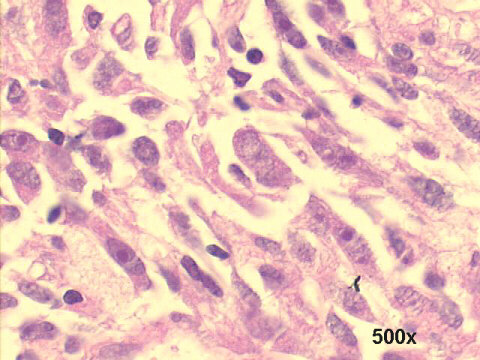
500x H&E staining

FNA cytology: many disperse dyscohesive anaplastic cells, several of them cigar-shaped; large bore needle biopsy reveals at H&E staining a fibrosarcoma with scant stroma. An extensive search for a primary tumor elsewhere in the body failed to find one. At definitive surgery, confirmation of the diagnosis, and immunohistochemical studies were ordered for final histological diagnosis, the differential diagnosis including monophasic synovial sarcoma, leiomyosarcoma, angiosarcoma, and neurofibrosarcoma. Immunohistochemistry was positive for vimentin, and negative for keratins, desmin, S100 protein, alpha-smooth muscle actin, CD31, and CD34.
Features of Lung fibrosarcoma Cellular patterns: |

| References |
|
Atlas |